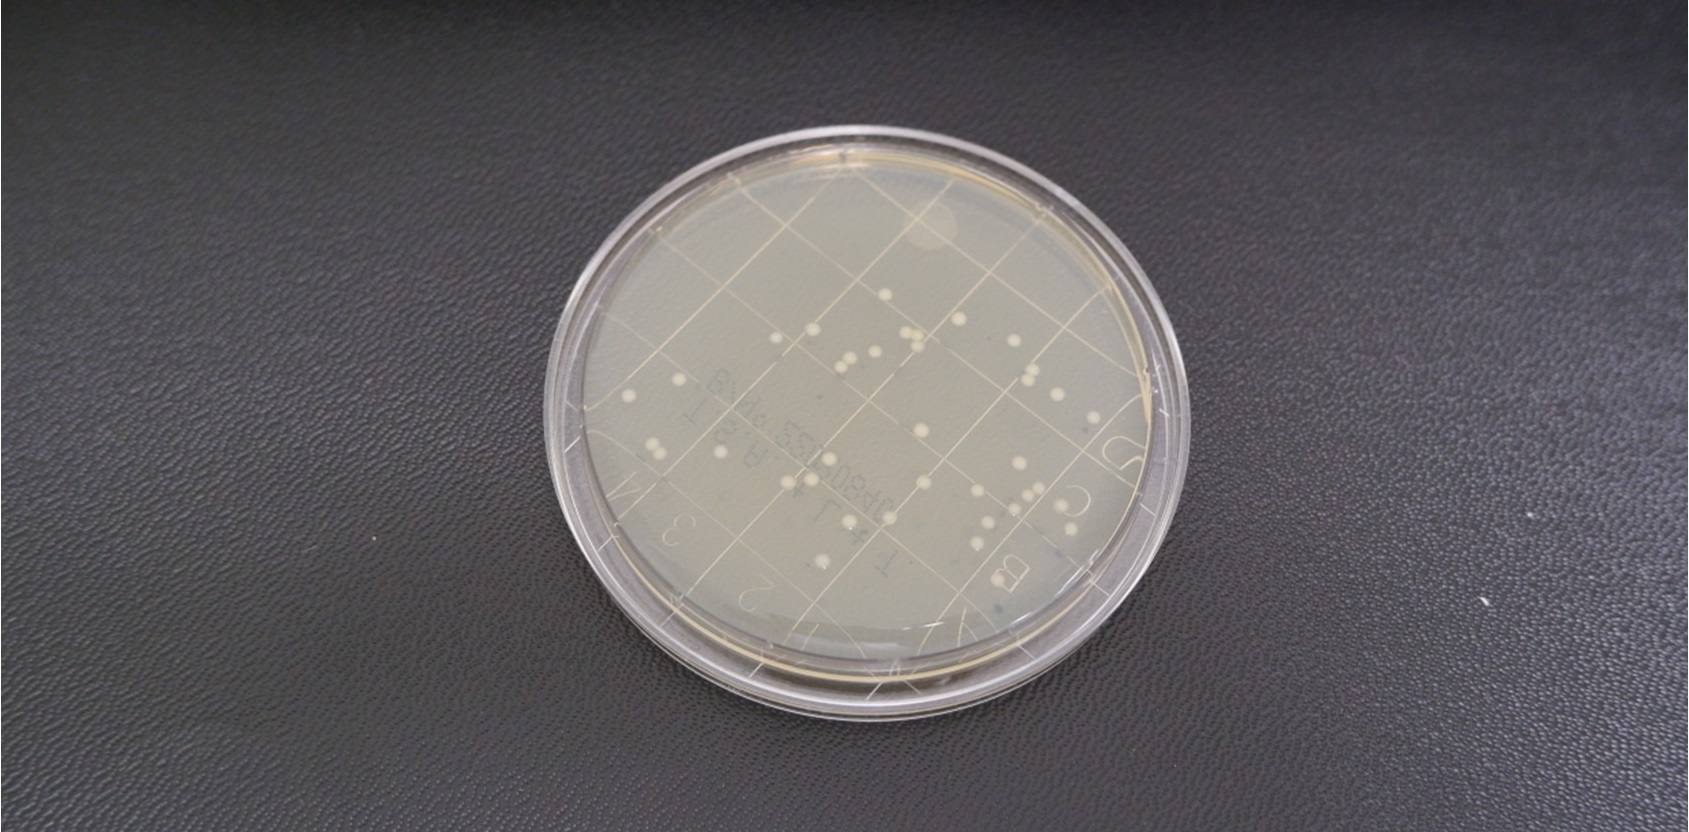
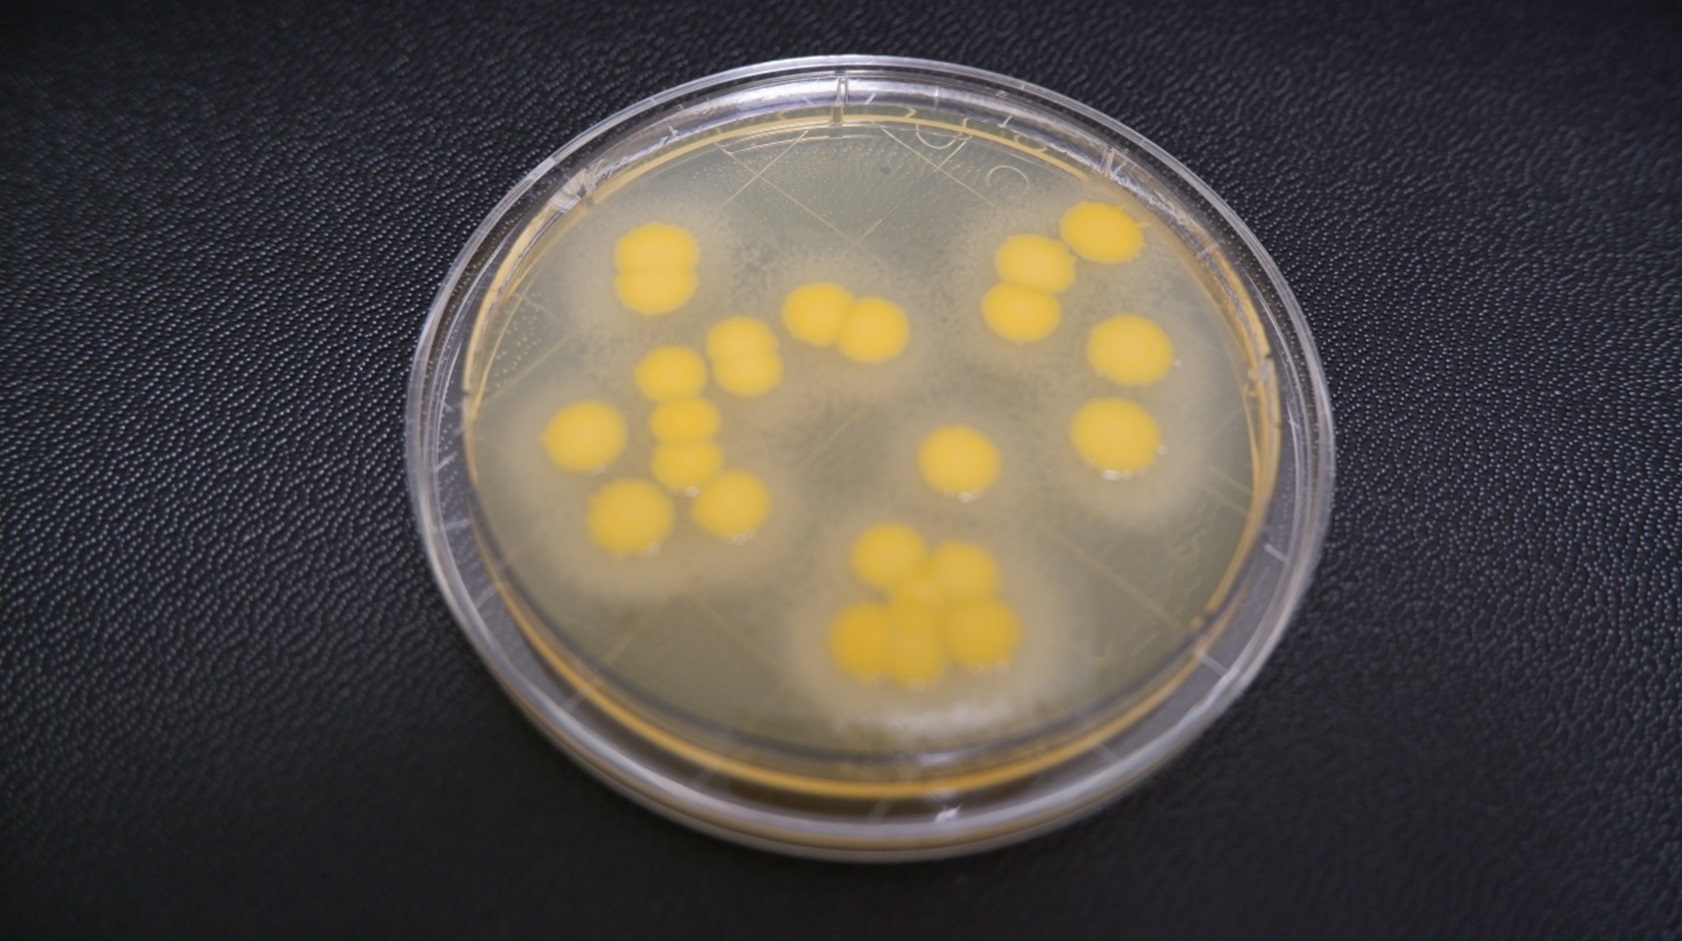
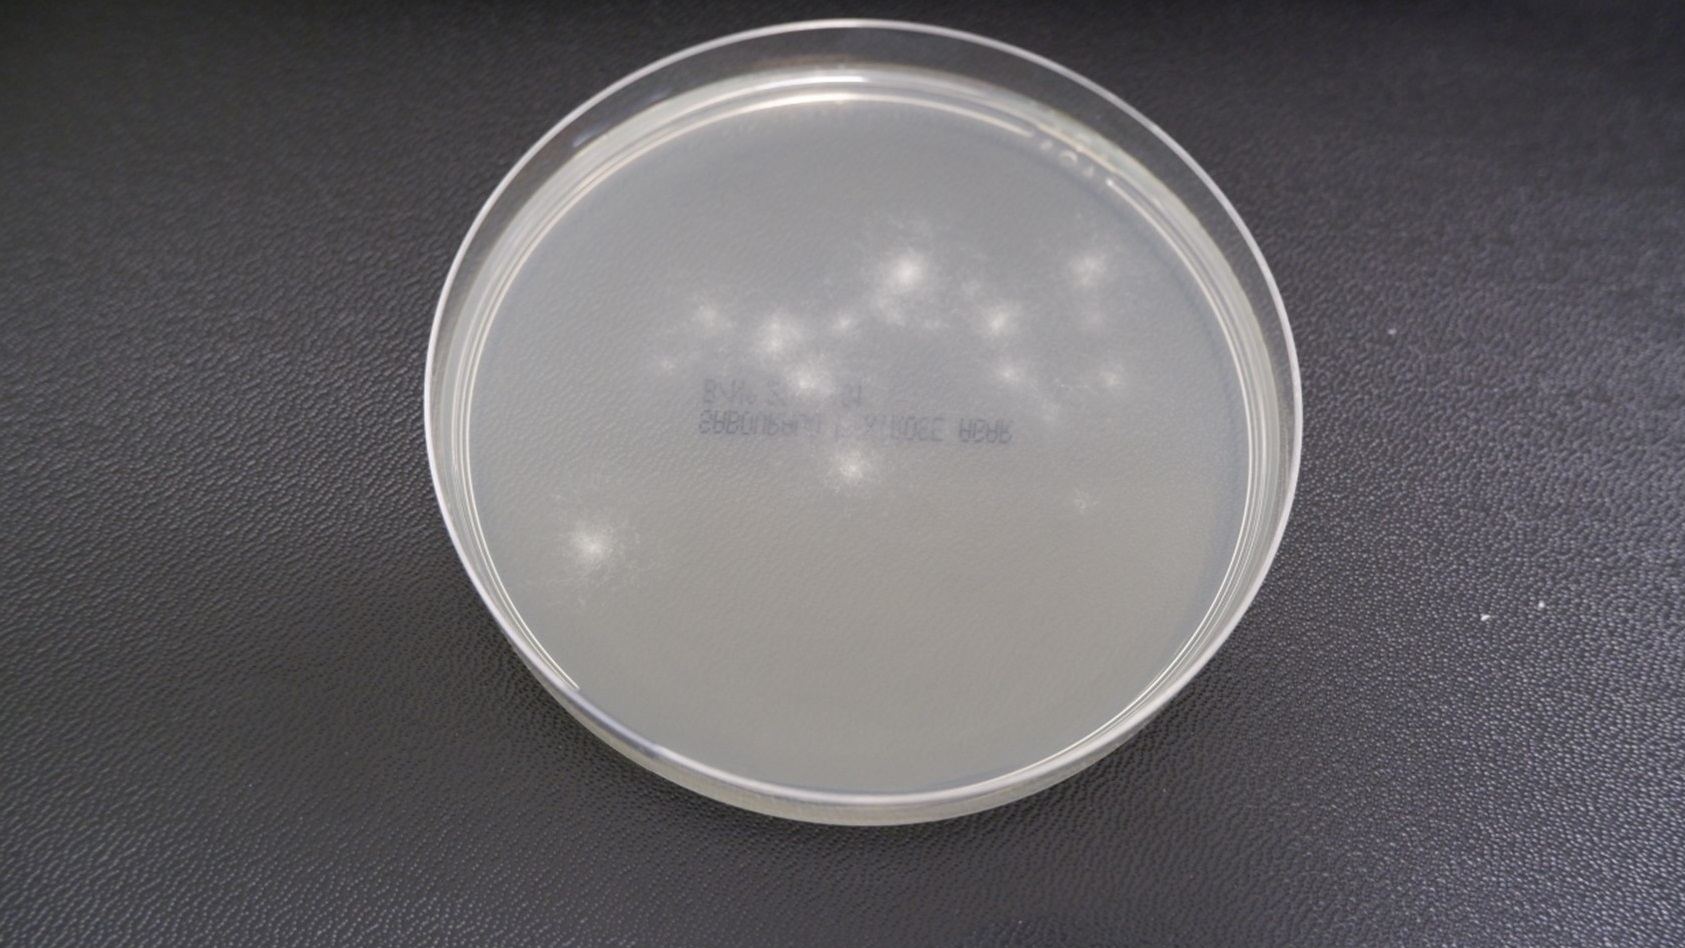
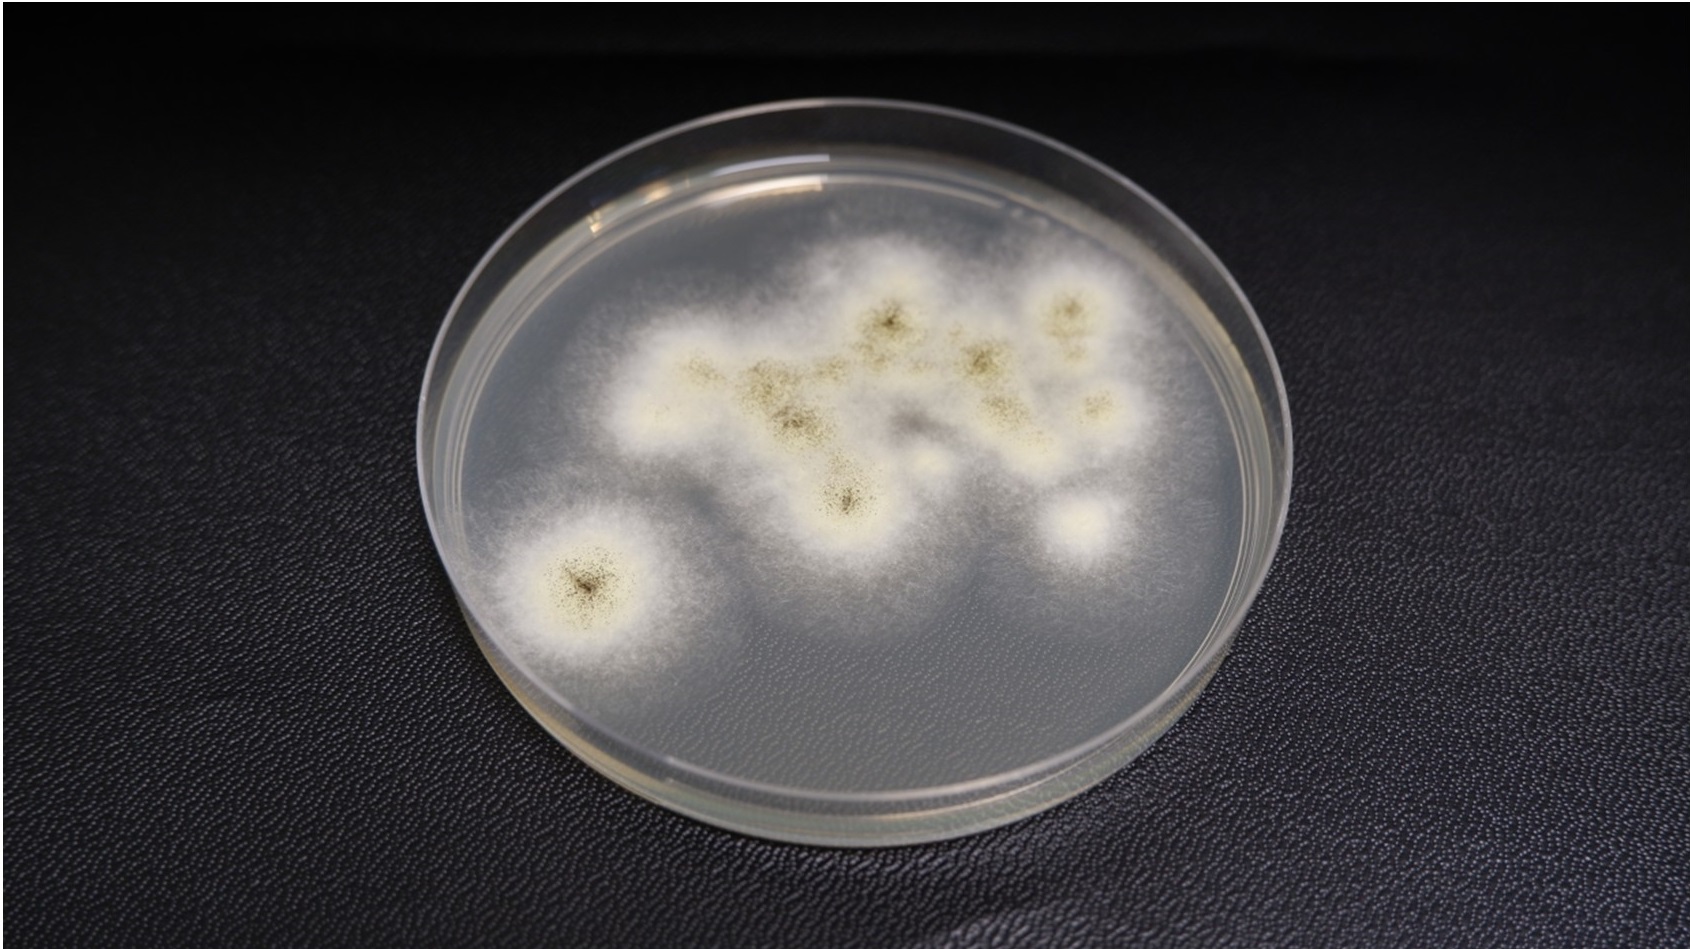
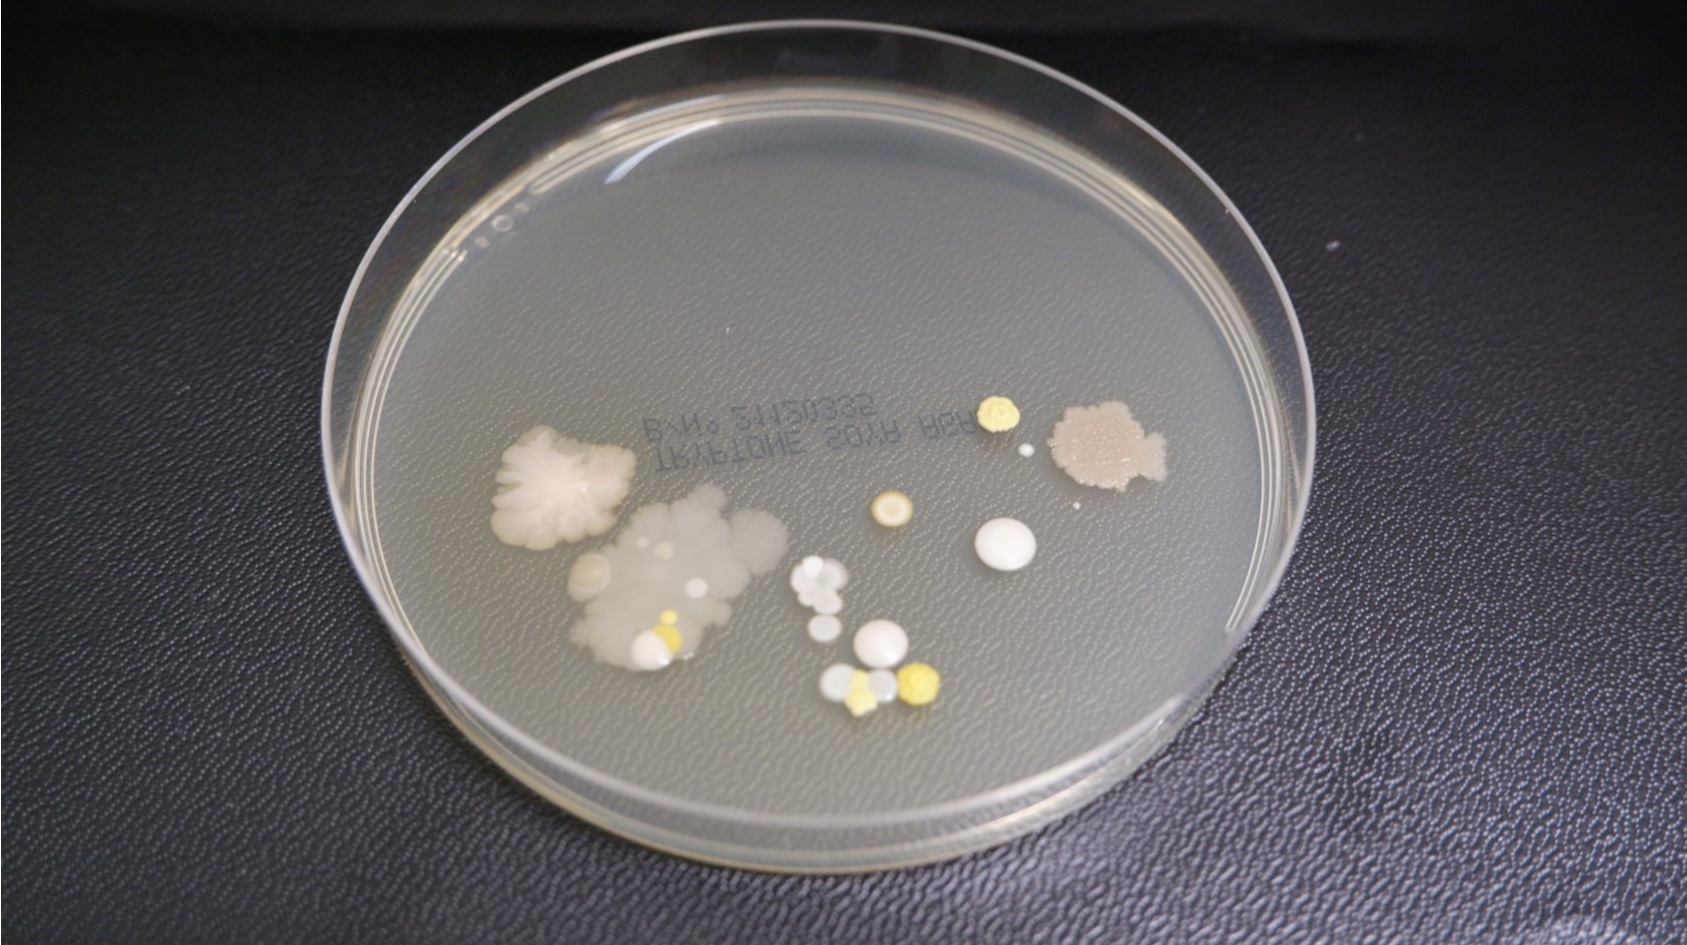

Environmental monitoring (EM) is essential for ensuring that cleanroom environments maintain the highest standards of cleanliness and are suitable for manufacturing sensitive products, especially in industries such as pharmaceuticals, biotechnology, and electronics.
Effective monitoring not only ensures product quality, but also serves as a critical data source when deviations or non-conformances occur.
A robust EM programme should provide insights into the types of microorganisms present in a cleanroom, their behaviour, and how these factors impact operations, such as the selection of disinfectants. So, the ability to identify viable bacteria and mould is crucial for preventing contamination and ensuring the effectiveness of cleaning regimes.
Both species showing similar growth patterns at five days, but with sufficient characteristic differences for accurate identification
This article delves into the practicalities of EM, focusing on the growth patterns of different organisms, culture media types, and the impact of incubation conditions. We'll explore the growth characteristics of common cleanroom contaminants and discuss how morphology shifts over time on various media.
Understanding these principles is essential for optimising microbial recovery rates and ensuring that cleanroom environments remain under control.
The role of environmental monitoring in cleanrooms
Environmental monitoring in cleanrooms primarily focuses on viable bacteria and fungi, ensuring that the microbial load remains within acceptable limits
The data collected play a pivotal role in releasing products, as cleanrooms must remain free of contamination in order to avoid product quality being compromised.
When deviations or non-conformances arise, EM data serve as reference points, allowing microbiologists and quality control (QC) staff to investigate the source of contamination, the effectiveness of disinfectants, and the overall hygiene of the environment.
Dual incubation regimes are often implemented to reduce the need for additional EM plates
Each of the methods used in cleanroom monitoring – the collection of air samples, surface swabs, and settling plates – helps build a comprehensive profile of the cleanroom environment, by highlighting trends and identifying potential sources of contamination.
These microbial profiles are often specific to an individual cleanroom, taking into account factors such as the activities carried out, the materials present, and even the operators working within the space. It's therefore critical to regularly review and update monitoring strategies in order to reflect any changes in cleanroom operations or layout.
Understanding the types of organisms isolated through EM is key. For example, common contaminants such as Staphylococcus aureus, Staphylococcus epidermidis, and Aspergillus species are often encountered. By studying the growth patterns of such organisms and how they change based on incubation conditions and media type, QC staff can make more informed decisions regarding contamination control and root cause analysis.
Morphology and incubation times: A case study
Let’s take Staphylococcus epidermidis, a Gram-positive cocci, as an example.
Following incubation on tryptic soy agar (TSA) at 24 hours incubation at 30-35°C, its colonies appear small, smooth, and regular in shape. This can make it challenging to distinguish between other bacteria that might be present on the plate. However, after an additional 24 hours of incubation, the colonies become more distinct, exhibiting typical characteristics, such as larger size and classic morphology (Figure 1).

Figure 1: Incubating plates - staph epidermidis and aureus
Therefore, incubation time can significantly influence the appearance of colonies. Another example is Staphylococcus epidermidis and Staphylococcus aureus – though belonging to the same genus – can be distinguished by their pigmentation after 48 hours of incubation at 30–35°C.
Over time, this visual differentiation becomes more apparent, with both species showing similar growth patterns at five days, but with sufficient characteristic differences for accurate identification. The morphology is a crucial part of microbial identification, whether this is used in conjunction with traditional phenotypic tests or alongside identification platforms.
Moulds spreading across plates will make the ability to record the number and identification of bacteria more challenging
This demonstrates how crucial incubation time and temperature is to effective bacterial identification. It must be noted that if plates are needing to be inspected frequently due to an investigation, reading plates at 24 hours might lead to misidentification or inaccurate results. Knowing those organisms which present better at greater than 48 hours provides clearer and more accurate results – a practice that QC staff should understand as part of their monitoring protocols.
The impact of media on morphology
In cleanrooms, the choice of media plays a critical role in the recovery of contaminants. TSA is a commonly-used medium, but when additional components such as Lecithin and Tween are introduced, they can impact on the morphology of recovered bacteria.
For instance, Staphylococcus aureus grown on TSA with lecithin and Tween at 24 and 48 hours exhibits similar morphology to TSA without additions. However, by day five, the media additives can cause morphological changes, which can complicate phenotypic identification (Figure 2). This underscores the importance of understanding the impact of media on microbial growth.
Figure 2a - Incubating plates - staph aureus TSA L + T 24hour
Figure 2b Incubating plates - staph aureus TSA L + T 5 days
Dual incubation regimes and their effects
Dual incubation regimes are often implemented to reduce the need for additional EM plates. One set of plates is first placed at a temperature of 20-25°C and following five day incubation, these plates are read and moved to a 30-35°C incubation for 48 hours, or variations of this. This practice ensures the detection of both environmental bacteria and fungi. This may play a role in influencing colony morphology. Again, QC staff should understand how incubation conditions affect the organisms they are monitoring. This knowledge equips them to make better decisions, when choosing media and incubation protocols, to optimise the recovery of viable microorganisms.
Fungal growth will present differently on TSA and SDA at 20-25°C and the ability to see colonies can be more challenging on TSA.
Effective monitoring not only ensures product quality, but also serves as a critical data source when deviations or non-conformances occur
The length of incubation time is important to ensure the visibility of all viable fungal organisms. A risk that may pose a challenge when fungi are present is more rapid growth when TSA plates are moved to the 30-35°C incubation.
Moulds spreading across plates will make the ability to record the number of bacteria on the plate, along with the identification of these, more challenging. This challenge isn’t restricted to plates exposed to dual incubation, fungal growth can be rapid and present the same challenge on TSA when single incubation is used, where plates are incubated at 30-35°C.
Monitoring mould growth in cleanrooms
Mould contamination is a significant concern in cleanroom environments. When these are present on EM plates this can impact on the ability to read the plates effectively.
For example, when plates are incubated for 48 hours, Aspergillus may occupy only a portion of the agar plate, but by day five, its growth can cover the entire surface; this makes it almost impossible to identify any bacterial growth that might also be present (Figure 3).
Figure 3a -Incubating plates - Aspergillus
Figure 3b - Incubating plates - Aspergillus 4 days
As with bacteria, the choice of media can influence mould morphology. On TSA with lecithin and Tween, Aspergillus exhibits even more rapid growth than on standard TSA, quickly covering the plate and potentially masking the presence of other organisms. It's therefore crucial to evaluate environmental plates regularly during incubation to avoid missing critical contamination events. Another important consideration is the environmental conditions that promote mould growth.
A robust EM programme should provide insights into the types of microorganisms present in a cleanroom
Cleanrooms must be monitored for humidity and temperature, both of which can influence fungal contamination. If humidity levels are too high, mould growth can become uncontrollable, even with stringent cleaning and disinfection protocols. Monitoring and controlling these environmental parameters are essential to keeping mould contamination under control.
Recognising atypical growth patterns
QC staff must also be able to recognise atypical growth patterns that may result from accidents or deviations during EM.
For example, plates that have been inadvertently dropped or touched by operators will exhibit unusual growth patterns, and present organisms that may have not been witnessed before. Recognising these outliers is important for correctly interpreting and trending EM data to enable risk to product to be correctly evaluated.
For instance, a plate contaminated by accidental contact may show irregular, clustered growth that is unlike the smooth, even distribution typical of cleanroom contaminants (Figure 4). These insights are valuable during investigations of out-of-trend results and help ensure that corrective actions are targeted and effective.
Figure 4 - Incubating plates - irreg clustered growth
By understanding the typical growth patterns expected from environmental isolates, microbiologists can more readily identify when something is out of trend, and gain assurance nothing has been missed.
The choice of media is important, along with the incubation time and temperature. This is to ensure that when a plate presents no growth, this is a true representation of no environmental risk to product and not a result of a false negative due to the environment which the organism requires to grow being compromised.
Optimised environmental monitoring
Effective EM is fundamental to maintaining cleanroom control and ensuring product quality.
The ability to understand how colony morphology changes over time, under different incubation conditions, and on various media types is crucial for identifying contaminants and preventing contamination. QC staff must be equipped with the knowledge and skills to interpret EM data accurately, considering factors such as incubation time, media composition, and the potential for dual incubation regimes to affect microbial recovery.
In cleanrooms, the choice of media plays a critical role in the recovery of contaminants
By optimising EM practices for microbial contamination, cleanrooms can remain under control, ensuring that final products meet the highest standards of quality and safety. The insights gained from careful observation of growth patterns and colony morphology provide greater confidence in the recovery of viable bacteria, support investigations into root cause analyses, and guide the implementation of corrective actions to prevent future deviations.
In industries where contamination can have significant consequences, these practices are essential for maintaining the integrity of cleanroom environments and ensuring the consistent delivery of safe, high-quality products.